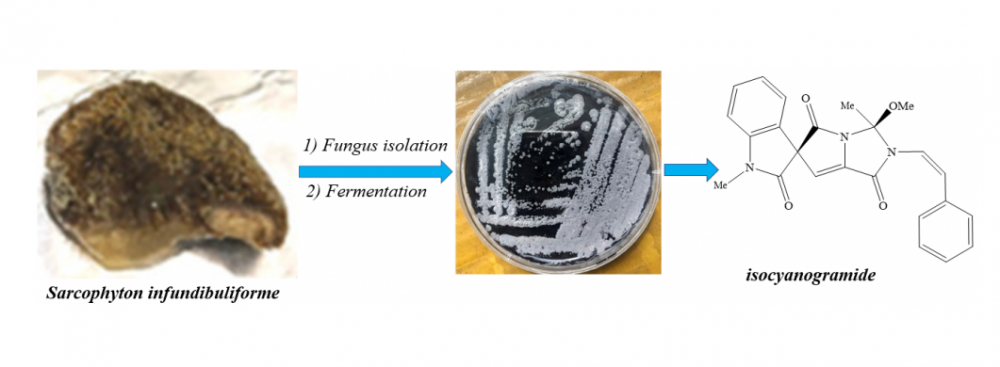

Records of Natural Products
Year: 2023 Volume: 17 Issue:6 November-December
1) Phytochemical and Pharmacological Studies of Natural Saponins from Platycodon grandiflorum

Platycodon grandiflorum (Jacq.) A.DC is a perennial single-species herb in the Campanulaceae family, and its dried roots have been widely used for a long time to diffuse the lung, soothe the throat, dispel phlegm, and expel pus as a Chinese traditional medicine. In addition, P. grandiflorum compounds are homologous to those in medicines and foods approved by the Ministry of Health of China, and many related foods have been marketed. It has been reported that the glycosides in pentacyclic triterpenoids, also known as saponins, are the main biologically active constituents of P. grandiflorum. This article offers a systematic review of recently reported saponins isolated from P. grandiflorum over the past decade covering the literature from the beginning of 2017 through the end of 2022 and describes their structural diversity and pharmacological studies. To the best of our knowledge, a total of 74 natural saponins have been isolated to date. For this review, 131 references on saponins were obtained, and the information from these articles is compiled herein. This review may be of interest to pharmacognosists and natural-product chemists. This review provides new ideas for the development and utilization of natural saponins for clinical applications in the future.
DOI http://doi.org/10.25135/rnp.409.2201.2328 Keywords Platycodon grandiflorum platycodin D pharmacological activity chemical constitution DETAILS PDF OF ARTICLE © 2023 ACG Publications. All rights reserved.2) Evaluation of Ligusticum jeholense Extracts for Skin Lightening

Natural materials in facial prescriptions has been practiced for thousands of years in China. Natural plant extracts are increasingly used in skin-whitening products. We found Gao-Ben (the rhizome and root of Ligusticum jeholense Nakai et Kitag, GB) was a common herb used in external whitening prescriptions by retrieving ancient Chinese medicine texts and modern traditional Chinese medicine(TCM) documents. Then, the functions of GB in topical application prescriptions for skin lightening were investigated. The essential oil of GB (GBO) were extracted by supercritical CO2fluid extraction (SFE-CO2), with the yield being 1.5%. The oil ingredients were analyzed by gas chromatography-mass spectrometry (GC-MS), and benzyl alcohol and ligustilide were major constituents, their relative contents were 55.3% and 35.7%. Then the enhanced penetration effects of GBO on test compounds, ferulic acid and ligustrazine were tested using the Franz diffusion cell. Finally, the changes in morphological features of rat skin treated with GBO were researched by computer-aided image analysis of haematoxylin and eosin (H&E) staining. This study indicates GBO can enhance skin penetration by changing the structure of the stratum corneum barrier. Therefore, the active components could be absorbed through the topical skin and exert the whitening effect.
DOI http://doi.org/10.25135/rnp.416.2306.2819 Keywords Ligusticum jeholense extract oil skin-hyperpigmentation transdermal promotor DETAILS PDF OF ARTICLE © 2023 ACG Publications. All rights reserved.3) Coumarins from the Dichloromethane Root Extract of Heptaptera triquetra and Their Cytotoxic Activities

A known dihydrofuranocoumarin ester; deltoin (1), together with five known sesquiterpene coumarin ethers; umbelliprenin (2), farnesyl scopoletin (3), karatavicinol (4), colladonin (5), colladin (6), and a novel sesquiterpene coumarin ether; 14′-hydroxybadrakemin (7) were isolated from the cytotoxic dichloromethane extract of the roots of Heptaptera triquetra. The cytotoxic activity of the isolated coumarins were evaluated against COLO205 (colon), KM12 (colon), A498 (renal) and UO31 (renal) cancer cell lines.
DOI http://doi.org/10.25135/rnp.415.2307.2846 Keywords Heptaptera triquetra Apiaceae coumarins cytotoxic activity DETAILS PDF OF ARTICLE © 2023 ACG Publications. All rights reserved.4) Structurally Diverse Terpenoids from the Resins of Populus euphratica

Phytochemical analysis of Populus euphratica resins has resulted in the isolation and identification of two undescribed terpenoids, including a new triterpene (1), a new sesquiterpene (2), and nine additional terpenoid (3-11) compounds. The structures of these novel compounds were determined using HR-ESI-MS and NMR (1D and 2D) spectroscopic analyses, combined with ECD calculations. The inhibitory activity of these terpenoids against α-glucosidase was also evaluated, and the results revealed that none of the compounds exhibited significant α-glucosidase inhibitory activity at a concentration of 50 μM. Only compound 1 displayed weak inhibitory activity (1.84 ± 8.96%) compared to the positive control.
DOI http://doi.org/10.25135/rnp.424.2306.2806 Keywords Populus euphratica resins sesquiterpenoids triterpenoids DETAILS PDF OF ARTICLE © 2023 ACG Publications. All rights reserved.5) Identification of the Genus Pleione Based on Fingerprinting and Determination of the Content of their Key Components









The genus pleione (Orchidaceae) is famous for its ornamental value because of the special color of plants, and it is also a traditional medicinal plant in southeast Asia. The genus is composed of 24 species and nine natural hybrids, with 16 species found in China, primarily in the southwestern, central, and eastern regions. The rich variations and transitional types within Pleione make its classification system confusing, and it is difficult to distinguish traditional morphological taxonomic characteristics. Therefore, this study utilized chemical taxonomy to classify Pleione for the first time. A total of 13 species of Pleione were collected to construct high-performance liquid chromatography (HPLC) fingerprints, and similarity evaluation and cluster and principal component analyses were conducted. Moreover, the distribution of chromatographic peaks in the pseudobulbs of Pleione was determined. The HPLC fingerprinting method for Pleione that was established is stable, feasible, and produces reliable results, which can provide a reference for taxonomic research in Pleione, The goal of this study was to more accurately and comprehensively develop and utilize the resources of Pleione.
DOI http://doi.org/10.25135/rnp.422.2308.2878 Keywords Pleione fingerprint chromatograms content determination DETAILS PDF OF ARTICLE © 2023 ACG Publications. All rights reserved.
6) A New Alkaloid from Marine-Derived Actinomycete Actinoalloteichus cyanogriseus G631

OA new alkaloid, isocyanogramide (1) together with six known compounds, including cyanogramide (2), marinacarboline F (3), marinacarboline H (4), caerulomycinamide (5), cerulomyconitrile (6), and 5ʹ-deoxyuridine (7) were isolated from the agar culture of the marine-derived actinomycete Actinoalloteichus cyanogriseus G631. Compounds 1-7 were evaluated for antimicrobial activity against Gram (+) bacteria, Enterococcus faecalis, Staphylococcus aureus, and Bacillus cereus, Gram-(–) bacteria, Escherichia coli, Pseudomonas aeruginosa, Salmonella enterica, and the yeast, Candida albicans. All compounds significantly exhibited antibacterial effects on three tested Gram-(+) bacteria and the yeast C. albicans with the MIC values ranging from 64 to 256 µg/mL. Compounds 4, 5, and 7 significantly inhibited B. cereus bacteria with MIC values of 16, 128, and 128 µg/mL, respectively.
DOI http://doi.org/10.25135/rnp.412.2305.2776 Keywords Actinoalloteichus cyanogriseus marine actinomycetes isocyanogramide alkaloid antibacterial activity antifungal activity DETAILS PDF OF ARTICLE © 2023 ACG Publications. All rights reserved.7) Chemical Composition and Anthelmintic Activity of the Peruvian Endemic Species Chuquiraga weberbaueri “Amaro” on Sheep Fasciolosis

















Chuquiraga weberbaueri “amaro” (Asteraceae) is a plant species popularly used for the treatment of animal fasciolosis in Peru. However, biological and chemical studies of this species remain scarce. Hence, the objective of the present study was to evaluate the anthelmintic effect of the hydroethanolic and aqueous extracts of C. weberbaueri leaves on Fasciola hepatica, through a controlled and a therapeutic efficacy test in artificially infected sheep. In addition, the chemical composition of the extracts was evaluated using phytochemical screening and analysis by UHPLC-MS/MS. Among the evaluated extracts, the aqueous extract proved to be the most efficient and of low toxicity against F. hepatica, inhibiting about 70% of its oviposition, using a 100 mg/kg dose. The chemical study showed that the major constituents were phenolic derivatives, such as chlorogenic acid and ethyl caffeate, with the notable presence of flavonoids, saponins, and lactones. Therefore, it was possible to observe the antihelmintic effect of the C. weberbaueri on the F. hepatica, which suggests the use of this plant extract as a potential alternative in the sheep fasciolosis treatment.
DOI http://doi.org/10.25135/rnp.414.2304.2751 Keywords Fasciola phytotherapy Chuquiraga bioactivity phenolics DETAILS PDF OF ARTICLE © 2023 ACG Publications. All rights reserved.8) Two New C21 Steroidal Glycosides from the Leaves of Hoya parasitica







Two new pregnane glycosides, parasiticoside A (1) and parasiticoside B (2), were isolated from the leaves of Hoya parasitica. Their structures were determined by spectroscopic analysis 1D and 2D NMR, and mass spectrometry (HR-ESI-MS in positive mode) techniques as 3β,20-dihydroxy-pregn-5-ene-3-O-β-D-fucopyranoside-20-O-β-D-glucopyranoside (1), and 3β,20-dihydroxy-pregn-5-ene-3-O-α-L-rhamnopyranosyl-(1→2)-β-D-fucopyranoside-20-O-β-D-glucopyranoside (2). These compounds are believed to be the first example of pregnane glycosides from a plant of the genus Hoya.
DOI http://doi.org/10.25135/rnp.419.2307.2831 Keywords Hoya parasitica Apocynaceae pregnane glycoside parasiticoside A parasiticoside B NMR DETAILS PDF OF ARTICLE © 2023 ACG Publications. All rights reserved.9) Metabolomics Profiling of Rhodomyrtus tomentosa (Ait.) Hassk. Leaves and Fruits Using 1H NMR Spectroscopy

Several studies have extensively documented the presence of metabolites with antibacterial, anticancer, antioxidant, and anti-inflammatory properties in extracts derived from Rhodomyrtus tomentosa fruits and leaves. Therefore, this study is aimed at evaluating the metabolite profile of R. tomentosa fruits and leaves at various maturity stages, as well as determining their phytomedicinal values. 1H NMR and chemometric analysis were used to conduct a metabolomics study to compare the metabolite profile and phytomedicinal values of different plant organs at varying ages. The leaves were classified into young and old categories, while the fruits were divided into three maturity stages, namely green, red, and purple. The wild-grown fruits and leaves of R. tomentosa (Ait.) Hassk were gathered in Banjarbaru, South Kalimantan Province, Indonesia. The multivariate analysis showed that choline, methionine, mannitol, and β-glucose compounds were three times higher in the fruits compared to the leaves. Meanwhile, the concentration of aspartate, myricetin, and quercetin compounds was three times higher in the leaves compared to the fruits. Secondary metabolites, including flavonoids, were identified in higher quantities in young leaves and green fruits compared to old leaves, as well as red and purple fruits.
DOI http://doi.org/10.25135/rnp.418.2307.2853 Keywords Rhodomyrtus tomentosa flavonoid 1H-NMR multivariate statistical analysis DETAILS PDF OF ARTICLE © 2023 ACG Publications. All rights reserved.10) Eupatorione A, an Unusual Sesquiterpenoid from the Aerial Parts of Eupatorium adenophorum

Herein, the chemical analysis of petroleum ether extract of Eupatorium adenophorum was conducted which led to the identification of a previously unreported sesquiterpenoid, named eupatorione A (1). The structure of eupatorione A (1) was elucidated through comprehensive spectroscopic analysis, including 1D, 2D-NMR techniques, as well as HRMS. Additionally, X-ray diffraction was employed to further confirm the structure. The anti-inflammatory activity of compound 1 was assessed by measuring its inhibitory effects on the production of nitric oxide (NO), induced by lipopolysaccharide (LPS) in RAW264.7 LPS-activated macrophages.
DOI http://doi.org/10.25135/rnp.23062807 Keywords Compositae Eupatorium adenophorum sesquiterpenoid chemical structure DETAILS PDF OF ARTICLE © 2023 ACG Publications. All rights reserved.11) A New Norsesquiterpene, Nor-bisabolan-1,11-diol, from Marine-Derived Fungus Trichoderma atroviride TD-8

One new norsesquiterpene and four known bisabolanes were obtained from the organic extract of Trichoderma atroviride TD-8 isolated from ocean sediments. Their structures were assigned by detailed interpretation of 1D/2D NMR and HRESIMS data, and they were determined to be nor-bisabolan-1,11-diol (1), (3R,6R,7R)-1,10-bisaboladien-3-ol (2), (3R,6R,7S)-1,10-bisaboladien-3,6-diol (3), (3R,6S,7R,10R)-1-bisabolen-3,10,11-triol (4), (3R,6R,7S,10R)-1-bisabolen-3,10,11-triol (5). Nor-bisabolan-1,11-diol (1) exhibited moderate cytotoxicity against HeLa and HCT-8 cell lines with IC50 values of 28.6 and 30.3 μM, respectively.
DOI http://doi.org/10.25135/rnp.413.2308.2871 Keywords norsesquiterpene bisabolane Trichoderma atroviride secondary metabolites cytotoxic activity DETAILS PDF OF ARTICLE © 2023 ACG Publications. All rights reserved.12) Chemical Composition, Antibacterial, Synergistic Antibacterial and Cytotoxic Properties of the Essential Oil from Gelsemium elegans (Gardner & Champ.) Benth.

This study aimed to analyze the chemical composition of the essential oil (GE-EO) isolated from Gelsemium elegans (Gardner & Champ.) Benth. aerial parts by GC/FID and GC/MS, and to evaluate its antibacterial, cytotoxic, and synergistic antibacterial properties. A total of 40 compounds were characterized, representing 95.1% of the total oil. The major constituents were identified as α-terpineol (18.8%), n-pentadecanal (11.5%), methyl hexadecanoate (7.2%), n-tetradecanol (5.2%) and linalool (4.1%). In microbroth dilution tests, GE-EO demonstrated antibacterial activities against Staphylococcus aureus, Bacillus subtilis, and Escherichia coli with minimum inhibitory concentrations (MICs) ranging from 0.16 to 0.32 mg/mL. In addition, significant synergistic effects were observed in both combinations of GE-EO with chloramphenicol and streptomycin. Based on the MTT assay, GE-EO was found to have broad-spectrum cytotoxicities against the A-549, MCF-7, HepG2, HCT-116, and HL-7702 cell lines with IC50 values ranging from 60.51 ± 1.08 to 159.56 ± 9.13 μg/mL.
DOI http://doi.org/10.25135/rnp.417.2308.2872 Keywords Gelsemium elegans essential oil antibacterial synergistic cytotoxic DETAILS PDF OF ARTICLE © 2023 ACG Publications. All rights reserved.13) A New Ergosterol-Type Steroid Isolated from the Nicotiana tabacum-Derived Endophytic Fungus Aspergillus sp. TE-65L

Chemical study on the fungal strain Aspergillus sp. TE-65L, which was previously isolated from cultivated tobacco (Nicotiana tabacum L.), led to the production of four steroids including a new ergosterol-type steroid, namely aspergosterol A (1). Their chemical structures were established by detailed spectroscopic analysis of 1D/2D NMR and HRESIMS data. Compound 1 was found to possess anti-phytopathogenic activities against Alternaria alternate, Botrytis cinerea, and Fusarium oxysporum, with MIC values of 4, 8, and 16 μg/mL.
DOI http://doi.org/10.25135/rnp.420.2309.2909 Keywords Aspergillus sp. endophytic fungus secondary metabolite steroid antifungal activity DETAILS PDF OF ARTICLE © 2023 ACG Publications. All rights reserved.14) A New Chromanone Derivative from Calophyllum inophyllum Resin and Its Antibacterial Activity

A new chromanone derivative, calophylloidic acid B (2), was isolated from Calophyllum inophyllum resin in Lombok, Indonesia. The structure of the new compound was elucidated as a structural isomer of calophylloidic acid A (1), which we had previously isolated from Indonesian C. inophyllum resin. It exhibited potent antibacterial activity against Staphylococcus aureus and Escherichia coli.
DOI http://doi.org/10.25135/rnp.421.2308.2890 Keywords chromanone Calophyllum inophyllum calophylloidic acid Indonesia antibacterial activity DETAILS PDF OF ARTICLE © 2023 ACG Publications. All rights reserved.15) 5,6-dihydroxypyranoflavone, a New Flavonoid with an Oxidized Prenyl Group from Dietary Plant Citrus hystrix

Citrus hystrix has been widely used as beverages, traditional condiments and folk medicines. In this study, 5,6-dihydroxypyranoflavone (1), a new flavonoid with an oxidized prenyl group, and three known phenols (2-4), were separated from the leaves of this plant. Their structures were elucidated using comprehensive spectroscopic data including 1D NMR, 2D NMR and mass spectral analysis. Additionally, 5,6-dihydroxypyranoflavone (1) exhibited moderate antioxidant effect against DPPH and ABTS free radicals with IC50 values of 18.28 ± 0.36 and 12.46 ± 0.82 μM, respectively. The results suggested that the dietary plant Citrus hystrix could be considered as a potential source of natural antioxidants.
DOI http://doi.org/10.25135/rnp.423.2309.2904 Keywords Citrus hystrix dietary plant flavonoid antioxidant effect DETAILS PDF OF ARTICLE © 2023 ACG Publications. All rights reserved.